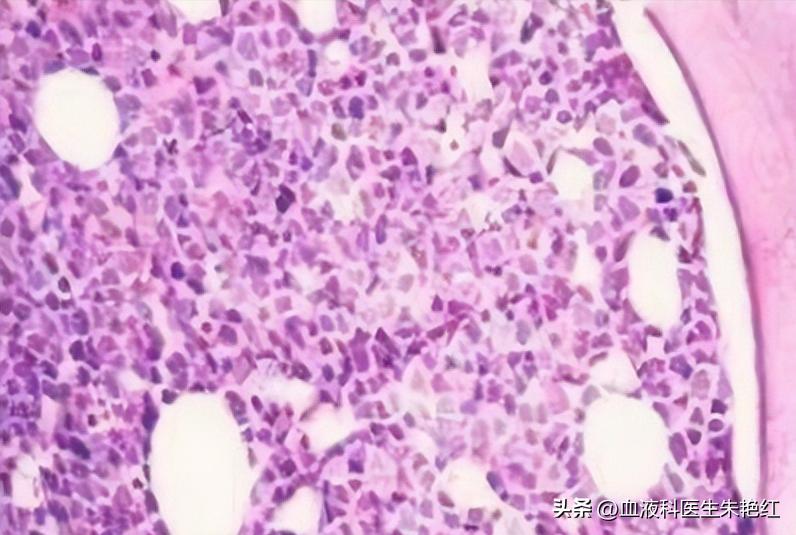
MDS白细胞低怎么治疗？有哪些注意事项？

MDS的主要特征就是无效造血、难治性血细胞减少、造血功能衰竭,因此,绝大多数患者都会出现血象异常。有些患者早期血象波动不大,但由于治疗药物的影响容易出现骨髓抑制,出现血象进一步下降。

对于血象比较低的MDS患者,尤其是白细胞持续低下的患者,整体免疫功能异常,很容易受到外界不良因素的影响出现感染发热的现象,对后续的治疗和整体预后都有影响。
MDS白细胞低怎么治疗?
有哪些注意事项?
【治疗方面】
为避免发生严重的感染,及时提升白细胞和身体抵抗力非常重要。因此,白细胞低的时候,可遵医嘱使用升白针、升白药物治疗,如重组人粒细胞集落刺激因子,并且每日复查白细胞。
如果白细胞低下较为严重,升白针效果不佳,可在适合阶段进行多种药物联合治疗,以尽快提升血象为主要目的。
【日常防护】
除了积极的采取治疗措施之外,MDS患者还要做好平时的预防护理工作,特别是在白细胞低下的时候。
1、保持生活环境的整洁卫生,根据患者的具体情况,采用不同级别的无菌防护措施。
2、在生活中也需要避免接触有感冒,水痘,麻疹等具有感染性的人。MDS病人要注意尽量减少去公共场所,在人多的环境需要戴上口罩。

3、注意个人卫生。口鼻部位的卫生:每天需要检查鼻腔有没有发红?口腔里有没有红斑?溃疡?或是白色浮皮?餐前餐后以食用盐水或漱口液漱口。
4、注意腋下、肚脐、腹股沟等皱折处的清洗。随时保持会阴、肛门及生殖器的清洁与干燥。日常还需要保持大小便通畅,若有便秘或腹泻时需要及时告知医护人员。
综上所述,对于白细胞低下的MDS患者来说,容易导致感染问题。最直接的预防方式就是选择适合的治疗,尽快提升白细胞,其次就是生活中做好观察防护,帮助MDS患者顺利度过白细胞“低谷期”。

中西医结合治疗MDS更具优势
是更好的选择
中西医结合辩证施治MDS,单人单方,更具针对性。中西医结合治疗MDS增效减毒,降低西药耐药性,控制病情、延缓病情发展,提高MDS患者免疫力、降低复发概率。
关注【中医血液病医院】 cnxueyebing了解更多